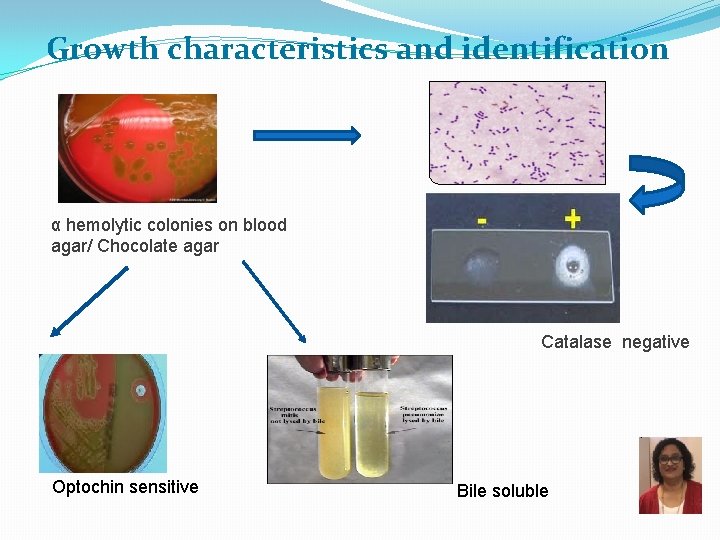
Growth characteristics and identification α hemolytic colonies on blood agar/ Chocolate agar Catalase negative
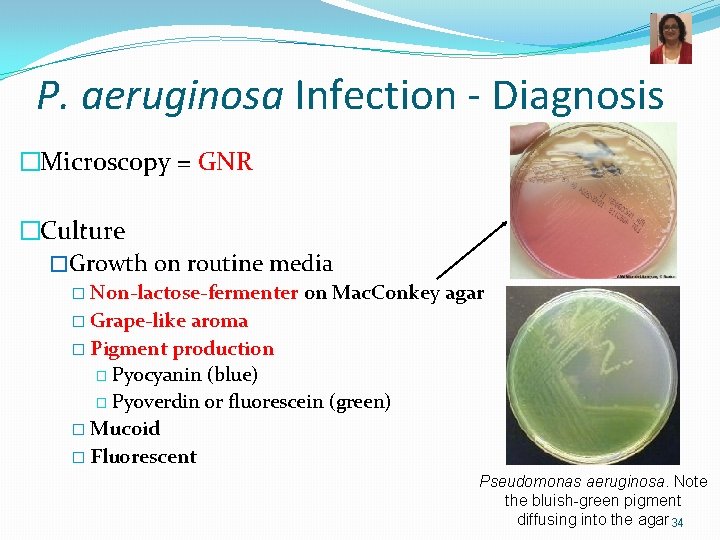
P. aeruginosa Infection - Diagnosis �Microscopy = GNR �Culture �Growth on routine media �
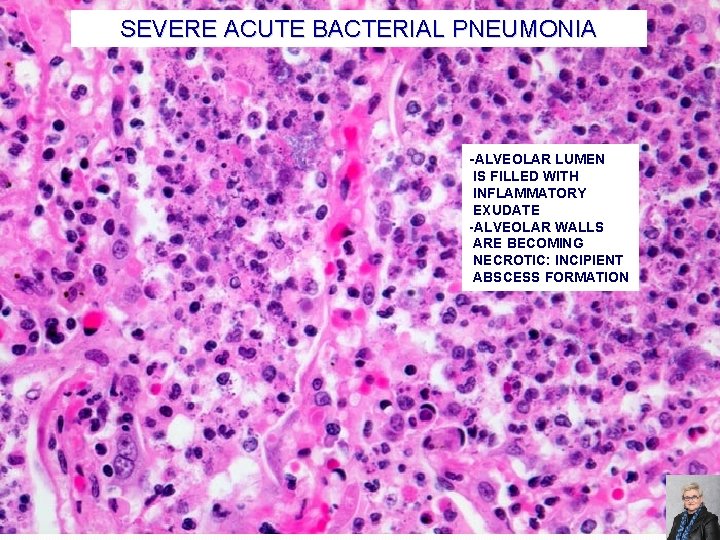
SEVERE ACUTE BACTERIAL PNEUMONIA -ALVEOLAR LUMEN IS FILLED WITH INFLAMMATORY EXUDATE -ALVEOLAR WALLS ARE
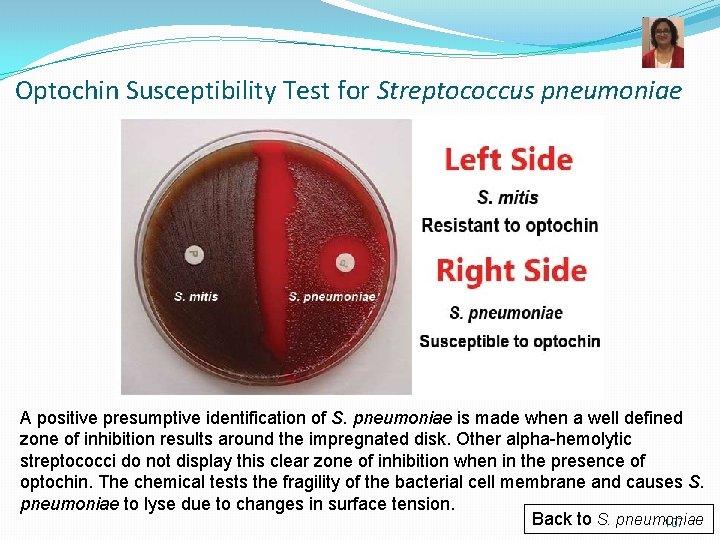
Optochin Susceptibility Test for Streptococcus pneumoniae A positive presumptive identification of S. pneumoniae is

Lower Respiratory Tract Infections Part 2 Bacterial infections

Lower Respiratory Tract Infections: Part 2 Bacterial infections The Respiratory Tract is the most common site of infection. It has direct contact with the outside environment and airborne pathogens.

Bacterial Infections of the Lower Respiratory Tract n Pneumonia q q q q • Pertussis ▫ Bordetella pertussis • Pulmonary Anthrax ▫ Bacillus anthracis * Previously discussed q q Streptococcus pneumoniae Mycoplasma pneumoniae Chlamydophila pneumoniae and psittaci Legionella pneumophila Coxiella burnetii Klebsiella pneumoniae Pseudomonas aeruginosa Moraxella catarrhalis* Haemophilus influenzae* Staphylococcus aureus* • Tuberculosis/TB-Like ▫ Mycobacterium tuberculosis ▫ Other acid-fast bacilli 2

Bacterial Pneumonia A Clinico-Microbiological correlation 3

Types of Pneumonia Clinical findings Onset Acute Chronic Typical pneumonia Atypical pneumonia Setting Community acquired Nosocomial

Based on the setting in which the infection was acquired… Pneumonia NOSOCOMIAL COMMUNITY ACQUIRED ASPIRATION PNEUMONIA

Community acquired Typical vs Atypical pneumonia Typical Atypical Ø Pneumonia with typical features Ø C/F: high fever, chest pain, cough which is usually productive, shortness of breath, lobar consolidation on Chest Xray Ø Bacteria: � Streptococcus pneumoniae � Hemophilus influenzae � Klebsiella pneumoniae � Moraxella catarrhalis � Staphylococcus aureus Ø Pneumonia with atypical features Ø C/F: Less severe illness, dry cough, headache, and other systemic complaints, patchy bronchopneumonia Ø Bacteria: � Chlamydophila species � Mycoplasma pneumoniae � Legionella pneumoniae � Coxiella burnetii Ø Viruses

Causes of Nosocomial pneumonia Gram negative bacteria: Pseudomonas, Acinetobacter Klebsiella, E. coli, Serratia Gram positive organisms: Staphylococcus aureus Nocardia Fungi Aspergillus Mucor/ Rhizopus Viruses: CMV Risk factors • Recent hospitalization of at least 2 days • Nursing home or long-term care facility resident • Recent intravenous antibiotic therapy, chemotherapy or wound care • Ventilator-associated pneumonia • Post-transplant patients • Immunocompromised

Aspiration Pneumonia Inflammation of the lungs from inhalation of foreign material (food, liquids, vomit) or from fluids from the mouth. Microaspiration Pneumonia Occurs frequently in most people. Usually asymptomatic. � Predisposing conditions � Any condition associated with altered or reduced consciousness (e. g. after a stroke, while sleeping) � While vomiting � Condition causing abnormal gag and swallowing reflexes (e. g. neurological dysfunction) � Etiologic agents � Normal flora of oropharynx � Oral anaerobes: Prevotella, Fusobacterium spp. , Peptostreptococcus* � Streptococci * Anaerobes will be � Clinical presentation: covered in GERD � Chemical irritation � Due to toxic substances (e. g. gastric acid) � Bacterial infection (frequently polymicrobial) � Often necrotizing with fulminant course 8

Community Acquired pneumonia: Underlying conditions correlated with etiological agents Healthy individuals with no predisposing factors Alcoholics and vagrants Streptococcus pneumoniae Mycoplasma pneumoniae Chlamydophila pneumoniae Streptococcus pneumoniae Klebsiella pneumoniae M. tuberculosis Underlying condition–COPD/ Viral infection Streptococcus pneumoniae Hemophilus influenzae Staphylococcus aureus Underlying condition–Cystic Fibrosis Pseudomonas aeruginosa Staphylococcus aureus H. influenzae HIV positive patients Mycobacterium tuberculosis Atypical mycobacteria Pneumocystis jirovecii CMV

Community Acquired Pneumonia Occupational exposure • Aerosols/air conditioning/ cooling towers • Legionella pneumophila • Veterinarian/Farmer: Coxiella burnetii • Animal hide porters, Wool sorters, Abbatoir worker • Bacillus anthracis Travel exposure • Specific states in the USA associated with • Dimorphic fungi • Developing countries • M. tuberculosis • South East Asia/ South and central America • Burkholderia pseudomallei Exposure to animals/birds • Infected birds • Chlamydophila psittaci • Cryptococcus neoformans • Avian flu • Pigs: Swine flu • Bat and bat droppings: • Histoplasma capsulatum • Infected sheep, goats and cattle : Coxiella burnetii-Q fever • Brucella spp • Rodents • Hantavirus

Typical Pneumonia Streptococcus pneumoniae Klebsiella pneumoniae Pseudomonas aeruginosa 11

Pathogenesis of Bacterial Pneumonia Invasion Damage Immune Response Spread • Pathogen enters alveoli from throat, nose, airborne droplets, blood • Multiples and invades alveolar epithelium • Avoids phagocytosis (e. g. capsule or intracellular growth) • Tissue injury via exotoxin production, host cell lysis, death of alveolar macrophages, etc. • Inflammation fever, chills, fatigue • ↑ PMNs, serum components, alveolar macrophages • Fluid accumulation and bacterial multiplication in alveoli • Spread of pathogens to nearby alveoli • Radiologic evidence of infection consolidation 12

Streptococcus pneumoniae (Pneumococci) Infections � Most common cause of bacterial community-acquired pneumonia � Most common cause of otitis media and sinusitis in children � Also causes bronchitis, septicemia, meningitis � Reservoir = humans upper respiratory tract � Transmission/Infection � Endogenous: aspiration of normal flora � Exogenous: via respiratory droplets 400, 000 hospitalizations/year in the US 36% of adult communityacquired pneumonias � Predisposing factors for pneumococcal pneumonia � Recent viral respiratory infection � Age > 60 years; unvaccinated infants � Sickle cell disease � Asplenic 13

MORPHOLOGY OF S. pneumoniae Gram positive cocci arranged in pairs or chains. Flame shaped/ Lanceolate. Capsule + India ink preparation Showing capsulated forms of S. pneumoniae Gram stain of sputum showing inflammatory exudate with GPC in pairs

Growth characteristics and identification α hemolytic colonies on blood agar/ Chocolate agar Catalase negative Optochin sensitive Bile soluble

Virulence factors and Pathogenesis Colonization on nasopharyngeal epithelial cells Surface protein adhesins Aspiration and migration Impaired clearance mechanisms Secretory Ig. A protease Phagocytic survival Polysaccharide capsule block phagocytosis. 90 serotypes, 23 responsible for most infections Tissue destruction Immunity brought about by anti- capsular antibodies leading to classical pathway complement deposition Pneumolysin –pore-forming cytotoxin Released from autolysed S. pneumoniae Damages respiratory epithelium Peptidoglycan/teichoic acids Inflammatory

Progression of Pneumococcal Disease Capsule prevents phagocytosis; Toxins damage lung cells Infection of lung Pneumonia Infection of eustachian tube/ sinuses Otitis media/ Sinusitis Bacteremia, meningitis Colonization of nasopharynx The outcome of colonization depends on the virulence of the specific serotype and on the host immune system 18

Streptococcus pneumoniae Virulence Factors � Polysaccharide capsule – essential for virulence � Antiphagocytic � 90 serotypes, 23 responsible for most infections � Ig. A protease � Colonization � Autolysin � Release of intracellular virulence factors and cell wall fragments � Pneumolysin –pore-forming toxin � Released from autolysed S. pneumoniae � Damages respiratory epithelium � Peptidoglycan/teichoic acids � Inflammatory Damage of epithelium stimulates outpouring of fluid, red blood cells, and leukocytes from alveoli productive cough with blood 19

Pneumococcal Pneumonia: Typical Lobar Pneumonia �Fever with shaking chills �Productive cough with blood tinged sputum (rusty sputum) �Chest pain, shortness of breath �fatigue 20

Pneumococcal Pneumonia - Diagnosis �Microscopy – Gram Stain �GPDC, lancet-shaped �Culture – blood agar � -hemolytic �Optochin (P disk) sensitivity �Catalase negative �Bile soluble �Susceptible to lysis P �Antimicrobial sensitivity test �PCR Optochin disc test Res Sus Bile solubility 21

S. pneumoniae – Capsule Typing �Quellung reaction �Identification of S. pneumoniae serotype �Capsular swelling upon binding of type-specific antibody �Latex particle agglutination �Detection of capsular antigen by mixing patient CSF with antibody coated latex beads 22

Pneumococcal Infections Treatment n Treatment: n n Beta-lactams = penicillin or 3 rd generation cephalosporin, clindamycin, vancomycin Resistance to penicillin is now common altered penicillin-binding proteins - all S. pneumoniae isolates should be tested for susceptibility to beta-lactams Pneumococcal Infections Prevention n PPSV: pneumococcal polysaccharide vaccine = 23 -valent polysaccharide vaccine n PCV: pneumococcal conjugate vaccine = 13 -valent conjugated vaccine for children < 60 months 23

Typical Pneumonia Streptococcus pneumoniae Klebsiella pneumoniae Pseudomonas aeruginosa 24

Grouping of important Enterobacteriaceae Mac. Conkey’s agar Lactose fermenters E. coli Klebsiella Non lactose fermenters Salmonella Shigella Proteus Yersinia

K. pneumoniae- Morphology and Growth �Morphology: Gram negative bacilli, short and plump. �Capsulated. �Nonmotile �Mac Agar: large, mucoid, lactose fermenting colonies �Oxidase negative Gram stain showing polymorphs with Plump/ short Gram negative capsulated bacilli Pink and mucoid colonies of Klebsiella on Mac Conkey’s agar

Epidemiology, Pathogenesis, Clinical presentations, Treatment � Common bacterial flora of intestine. � Pathogenesis due to Capsule and endotoxin production. � Necrotic destruction of tissue abscesses = hard to treat � Predisposing conditions: alcoholism, diabetes, age, chronic respiratory disease. � Necrotizing pneumonia: frothy, mucoid and bloody sputum ‘currant jelly sputum’. � Other infections � UTI: usually catheter associated. � Septicemia : infected IV lines. � Wound infections. Treatment: 3 rd generation cephalosporins w or w/o Aminoglycosides. Fluoroquinolone.

Study Tip �Klebsiella pneumoniae �The four “A’s” �Aspiration �Abscess �Alcoholics �di-A-betics 28

Pseudomonas aeruginosa 29

A 14 -year-old returns to the cystic fibrosis clinic after a two-year absence complaining of thick green sputum, breathlessness, generalized lethargy and weight loss. He was diagnosed with cystic fibrosis since the age of two. Repeated cultures of sputum on Mac Conkey’s is likely to grow which of the following organisms ? 1. Hemophilus influenzae 2. Staphylococcus aureus 3. Pseudomonas aeruginosa 4. Burkholderia cepacia 30

Pseudomonas aeruginosa � Aerobic GN motile rod with polar flagella � Produces pigments, grape-like fruity odor � Oxidase positive � Highly antibiotic resistant � Adaptability to minimal nutritional requirements Green pigment forming colonies on nutrient agar Ubiquitous in environment, especially water Transient colonization of humans Transmission Respiratory secretions Direct contact Fomites (e. g. respiratory equipment) Mac Conkey’s agar showing NLF colonies Oxidase positive

Pseudomonas aeruginosa • Attachment to epithelial cells via pili &/or adhesins Avoiding host defense Alginate (polysaccharide) capsule/slime layer formation of microcolonies protection from immune response Biofilm formation Inflammation Endotoxin/LPS • Tissue damage via extracellular enzymes and toxins Exotoxin A ADP-ribosylation of EF-2 stops protein synthesis cell death • Break down of host cells, tissues, proteins, lipids Elastase, alkaline phosphatase, phospholipase C, Exoenzyme S

Pseudomonas aeruginosa Infections �Opportunistic pathogen causing: �P = pneumonia, especially in cystic fibrosis patients and patients on ventilator �S = sepsis �E = external otitis (swimmer’s ear) �U = urinary tract infections �D = drug use and diabetics �O = osteomyelitis �Burn and wound infections � Nosocomial infections � Hot tub folliculitis 33
P. aeruginosa Infection - Diagnosis �Microscopy = GNR �Culture �Growth on routine media � Non-lactose-fermenter on Mac. Conkey agar � Grape-like aroma � Pigment production � Pyocyanin (blue) � Pyoverdin or fluorescein (green) � Mucoid � Fluorescent Pseudomonas aeruginosa. Note the bluish-green pigment diffusing into the agar 34

P. aeruginosa Infections Treatment �Resistant to many antibiotics �↓ permeability, ↑ efflux � Mutations and plasmid-mediated resistance �High dose aminoglycoside + either antipseudomonal beta-lactams (e. g. piperacillin-tazobactam) or ceftazidime, cefepime or carbapenem) or fluoroquinolone 35

Pseudomonas-like Bacteria �Stenotrophomonas maltophilia and Burkholderia cepacia Formerly classified in Pseudomonas genus Opportunistic pathogens Highly drug-resistant Associated with cystic fibrosis patients FYI 36

Pulmonary Anthrax Bacillus anthracis: • The agent of Anthrax • An agent used in biological warfare

Case Study- a dancer with breathlessness and cough…. �A 44 year-old professional musician and dancer for an African dance troupe presented to the emergency department c/0 shortness of breath, non-productive cough, chest pain, and diaphoresis x 2 days • Travel to Cote d’Ivoire in December • Significant findings: Temp 37. 6 C (99. 7 F), respiratory rate of 24 breaths/min, decreased breath sounds in the left lung • Blood cultures obtained 38

Case Study �Ceftriaxone and azithromycin therapy was initiated for presumed community-acquired pneumonia �A chest CT with contrast revealed a large amount of mediastinal fluid accumulation extending from the great vessels to the heart �Blood cultures positive for a gram-positive rod, identified as B. anthracis Patient obtained animal hides from Cote d’Ivoire Used animal hides to make drums Environmental cultures revealed B. anthracis Walsh et al, CID 2007: 44 (1 April) 39

B. anthracis as a weapon for biological warfare �Tried as a biological weapon by countries like Iraq, the former Soviet Union and the Aum Shinrikyo terrorist group in Japan. � 2001 - act of terrorism-contamination of envelopes mailed to senators- 22 U. S. P. S. staff affected. �CDC classifies it as a Category A biological agent 40

Gram positive rods Spore bearers Anaerobic Clostridia Aerobic Bacillus Filamentous Anaerobe Actinomyces Aerobic Nocardia Pleomorphic Corynebacterium Short rods Coccobacilli Listeria

Bacillus anthracis � Aerobic GPR � Spore-forming � Non-motile � Polypeptide capsule � Zoonotic – from herbivores • Classification of anthrax infections ▫ Dermal anthrax ~95% of cases ▫ Respiratory anthrax (wool-sorter’s disease) – inhalation of spores �Bioterrorism threat ▫ Gastrointestinal anthrax �Rare in humans, common in animals ▫ Sepsis - from primary infection 42

Bacillus anthracis � Ubiquitous / zoonotic, lives in soil � Causes anthrax in animals and humans § Large Gram positive bacilli § Arranged in long serpentine chains with a ‘jointed bamboo stick’ appearance or ‘Box car shaped’ morphology. § Forms endospores (not seen in clinical samples) § Non-motile § Has a polypeptide capsule made up of poly-d glutamic acid. � Culture- Blood agar: non hemolytic, large, irregular colonies with raised edge, ‘MEDUSA HEAD’ appearance. � Exotoxins- Anthrax toxin � Tripartite toxin Protective antigen Edema factor Lethal factor 43

Epidemiology � Cutaneous anthrax is common in leather industry workers and butchers. � Pulmonary anthrax- Bioterrorism- Classified as a ‘Category A’ biological agent Cutaneous anthrax Types of Anthrax Pulmonary anthrax Gastrointest inal anthrax Exposure to spores present in contaminated soil or in infected animal products (hide, hair and wool) AKA Hide Porter Disease/ Malignant pustule Inhalation of dust , filaments of wool AKA Wool Sorter’s Disease Consumption of infected meat All types may lead to septicaemia and meningitis

Respiratory (Inhalation) Anthrax Symptoms �Variable incubation (average 5 days) �Prodromal phase �Nonspecific, flu-like syndrome �Fulminant stage �Rapidly worsening course of fever, edema, enlargement of mediastinal lymph nodes �Respiratory distress, cyanosis, shock �Almost uniformly fatal within days 45

Pulmonary Anthrax – Pathogenesis n n n Inhalation of anthrax spores (infectious form) pulmonary alveoli Spores are phagocytized by alveolar macrophages where they germinate and replicate Transported through pulmonary lymphatics to mediastinal lymph nodes 46

Pulmonary Anthrax – Pathogenesis n Exotoxins production hemorrhage and edema in the lymph nodes and mediastinum: mediastinal hemorrhagic lymphadenitis q n n Mediastinal widening Pleural effusions and thickening of the bronchovascular bundles Ultimately, bacteria enter blood stream severe septicemia, meningitis and often death 47

B. anthracis spores in lung bronchiole B. anthracis - spore and vegetative stage n Endospore n n Protective, dormant form of a bacterial cell; resistant to environment Major component is calcium dipicolinate Stain with Malachite green B. anthracis spores can live in the soil for many years See Fundamentals lecture on Bacterial Cell Structure 48

Bacillus anthracis – Virulence Factors � Capsule composed of glutamic acid � Antiphagocytic � Carried on p. XO 2 plasmid � Anthrax exotoxin (tripartite in nature) � Edema factor (EF): adenylate cyclase � Lethal factor (LF): protease � Protective antigen (PA): mediates entry of EF and LF into host cell � Factors are not pathogenic individually, must combine � � PA + EF = edema toxin edema PA + LF = lethal toxin tissue necrosis � Toxins carried on p. XO 1 plasmid 49

Anthrax - Diagnosis �Microscopy �Gram stain = GPR, boxcars �Capsule: stained by M’Fadyean methylene blue stain or DFA �Spores: seen in malachite green stain �Culture on blood agar plate �Large, non-hemolytic adherent colonies �Molecular assays �PCR 50

Anthrax – Treatment and Prevention �Treatment �Ciprofloxacin �Prevention �Toxoid, cell-free vaccine used for high-risk persons �Vaccination of animals to control disease �Eradication unlikely because of spore production 51

Pathology of Bacterial Pneumonia 52

BACTERIAL PNEUMONIA �Definition: �Acute inflammation and consolidation of the lung due to a bacterial agent �Clinical signs and symptoms: �Fever and chills �Productive cough with rusty (bloody early in pneumococcal pneumonia), or yellow-green sputum �Tachypnea �Pleuritic chest pain �Decreased breath sounds, rales, and dullness to percussion 53

DIAGNOSIS OF BACTERIAL PNEUMONIA �Laboratory results: � Elevated peripheral blood WBC count with a left shift = increased neutrophils, with usually also increased number of young neutrophils (bands) � Sputum Gram stain positive � (Note: S. pneumoniae occurs in normal pharyngeal flora) � Blood cultures positive in 20 -30% patients �Chest x-ray: � Lobar pneumonia: � lobar or segmental consolidation � Bronchopneumonia: � patchy consolidation � Pleural effusion, if severe involvement 54

BACTERIAL PNEUMONIA IS AN ALVEOLAR FILLING DISEASE 55

LOBAR PNEUMONIA �Consolidation of entire lobe �Organisms: � Streptococcus pneumoniae (95%) � Klebsiella pneumoniae 56

NORMAL PNEUMONIA WITH PLEURAL EFFUSION FLUID LAYERING RLL PNEUMONIA AND PLEURAL EFFUSION 57

RUL LOBAR PNEUMONIA CONSOLIDATION OF AN ENTIRE LOBE 58

LOBAR PNEUMONIA; CLASSIC STAGES (AS SEEN IN PNEUMOCOCCAL PNEUMONIA) Congestion: �Heavy, boggy, red, hyperemic lungs with many bacteria but few neutrophils Red hepatization: �Massive confluent alveolar filling with RBCs, neutrophils, and fibrin Gray hepatization: �Disintegrating RBCs and fibrinopurulent exudate fill alveoli Resolution: �Macrophages mop up debris and normal function returns 59

LOBAR PNEUMONIA (FRESH LUNG) RED HEPATIZATION: AIRLESS, DENSE LUNG WITH MASSIVE CONFLUENT ALVEOLAR FILLING WITH RBCS, NEUTROPHILS AND FIBRIN. 2 ND DAY OF LOBAR PNUMONIA FIBRIN ON THE PLEURAL SURFACE 60

LOBAR PNEUMONIA (FRESH LUNG) RED HEPATIZATION IS TURNING TO GRAY HEPATIZATION: ALVEOLI ARE FILLED WITH DISINTEGRATING RBCs AND FIBRINOPURULENT EXUDATE. NOTE: THE AFFECTED LOBE DOES NOT COLLAPSE COMPLETELY BECAUSE OF THE INFLAMMATORY EXUDATE IN ALVEOLI. THE UNINVOLVED LUNG IS CONGESTED, BUT COLLAPSES, BECAUSE THE ALVEOLI ARE FILLED WITH AIR. 61

LOBAR PNEUMONIA (FIXED LUNG) GREY HEPATIZATION: CONSOLIDATED PALE LUNG DAY 4 -6 OF PNEUMOCOCCAL PNEUMONIA 62

LOBAR PNEUMONIA GREY HEPATIZATION CONSOLIDATED LUNG FIBRIN ON PLEURAL SURFACE 63

LOBAR PNEUMONIA, GREY HEPATIZATION ALVEOLI ARE FILLED WITH FIBRIN, EDEMA FLUID AND NEUTROPHILS 64

LOBAR PNEUMONIA, GREY HEPATIZATION -HYPEREMIA -EXUDATE WITH FIBRIN STRANDS AND PMNs FILLS ALVEOLI -SIDEROPHAGES: IRON-CONTAINING MACROPHAGES 65

LOBAR PNEUMONIA WITH FIBRINOUS PLEURITIS FIBRIN ON PLEURAL SURFACE CARBON IN SUBPLEURAL LYMPHATICS (PATIENT WAS A SMOKER) - HYPEREMIA - PMN’S IN ALVEOLI 66

BRONCHOPNEUMONIA Gross morphology: � Scattered patchy consolidation centered around bronchioles – “lobular” pneumonia � Usually bilateral, multilobar and basilar Epidemiology: � Affects the young, old, and terminally ill Organisms: � Staphylococci, Streptococci, Haemophilus influenzae, � Pseudomonas aeruginosa and others Microscopic features: � Acute inflammation of bronchioles and the surrounding alveoli 67

NORMAL BILATERAL BRONCHOPNEUMONIA PATCHY BILATERAL INFILTRATEES 68

BRONCHOPNEUMONIA (LOBULAR PNEUMONIA) BRONCHOCENTRIC YELLOW-WHITE CONSOLIDATED AREAS PURULENT MATERIAL IN THE AIRWAYS 69

ACUTE BACTERIAL PNEUMONIA -PATCHY CONSOLIDATION -CARDINAL SIGNS OF ACUTE INFLAMMATION ARE PRESENT: HYPEREMIA EDEMA PMNs IN THE ALVEOLI 70

THE “CARDINAL” SIGNS OF ACUTE BACTERIAL PNEUMONIA EDEMA PMNs IN ALVEOLI HYPEREMIA 71

SEVERE ACUTE BACTERIAL PNEUMONIA PMNs EDEMATOUS, HYPEREMIC ALVEOLAR WALL EDEMA 72
SEVERE ACUTE BACTERIAL PNEUMONIA -ALVEOLAR LUMEN IS FILLED WITH INFLAMMATORY EXUDATE -ALVEOLAR WALLS ARE BECOMING NECROTIC: INCIPIENT ABSCESS FORMATION 73

COMPARISON OF BRONCHOPNEUMONIA AND LOBAR PNEUMONIA 74

COMMUNITY ACQUIRED ACUTE BACTERIAL PNEUMONIAS SUMMARY: � S. pneumoniae most common cause - Distribution is usually lobar with intra-alveolar PMNs - Morphologic stages: congestion, red hepatization, gray hepatization, resolution � Other common causes: - H influenzae and M. catarrhalis (COPD) - S. aureus (post-viral superinfection; in IV-drug users together with right-sided staphylococcal endocarditis) - K. pneumoniae (chronic alcoholics; the most frequent cause of Gram-negative bacterial pneumonia) - P. aeruginosa (CF, burn patients, neutropenics) - L. pneumophila (organ transplant patients) 75

Atypical Pneumonia 76

Mycoplasma pneumoniae Legionella pneumophila Chlamydophila pneumoniae

Mycoplasmas- community acquired A 21 -yr-old university student complains of lethargy, headache, cough and a low grade fever with chills. When he was seen at the student health center, there was non productive cough along with shortness of breath on exertion. O/E his pulse rate was 95 beats / min and respiratory rate was 28 breaths/ min. Pharynx was erythematous. Chest examination revealed scattered rhonchi but no consolidation. Chest X-ray showed patchy infiltrates. Sputum examination revealed many inflammatory cells but no significant bacteria. Antibody tests showed high titers against a pathogen. 78

Mycoplasma pneumoniae Electron micrograph of M. pneumoniae. Arrows indicate P 1 adhesin location • Smallest free-living bacteria • No cell wall –very pleomorphic • Resistant to cell wall synthesis inhibitors • Not seen on gram stain • Cholesterol in membrane- Requires sterols to be added to the medium. • Extracellular pathogen and can be grown • Culture media: Mycoplasma agar, Eaton’s medium -colonies described as ‘ Fried Egg’ colonies Reservoir = human respiratory tract Pleomorphic forms of Mycoplasma: Spherical, pear shaped and filamentous forms 79

M. pneumoniae-virulence factors & pathogenesis Reservoir = human respiratory tract Transmission via respiratory droplets P 1 ADHESIN on tips binds to sialic acid residues on host epithelial cells Avoids host defense by hiding behind the cilia and prevents phagocytosis. Cessation of ciliary action Produce H 2 O 2 , superoxide radicals and enzymes that damage the respiratory epithelium Super-antigen effect: Il-2, IL-6 and TNF-a produced.

Mycoplasma-CLINICAL PRESENTATIONS Atypical pneumonia/ walking pneumonia ü Typically seen in school-aged children and young adult ü Seasonal variation: late summer and early fall ü Associated with laryngotracheobronchitis and myringitis ü Symptoms : sore throat, fever, headache, malaise, and a dry hacking cough which is usually mild and selflimited. ü Chest X ray : Unilateral or bilateral patchy lower lobe infiltrates � Complications: Ø Hemolytic anemia Ø Arthritis Ø Skin disorders: Steven Johnson syndrome Ø Raynaud’s phenomenon

M. pneumoniae-Lab Diagnosis and Treatment v Microscopy: not very helpful v Culture-very slow growth Eaton’s media Provides sterols Fried egg colonies, Mulberry colonies v Serological tests most commonly done. v Infection causes production of Ig. M autoantibody that agglutinates erythrocytes at 4°C but not at 37°C (non specific) v Complement Fixation Test for antibodies to M. pneumoniae v ELISA and Immunofluorescence v PCR or nucleic acid probes Fried egg colonies Mulberry colonies TREATMENT: Azithromycin or clarithromycin or tetracyclines (no cell wall active agents)

Pneumonia by Chlamydophila species 83

Chlamydiae-features and types • Small obligate intracellular bacteria • Possess an inner and outer membrane and lipopolysaccharide similar to the cell wall of gram-negative bacteria but do not have a peptidoglycan layer. Not seen on Gram stain • Do not make their own ATP and are energy parasites. • Do not grow on inanimate media. Need cell lines for growth- form cytoplasmic inclusions SPECIES OF HUMAN IMPORTANCE Chlamydophila pneumoniae Atypical pneumonia Chlamydophila psittaci Psittacosis/ Ornithosis Chlamydia trachomatis: Serotypes: A, B, Ba, C : Ocular infection-TRACHOMA D-K: Oculo-genital infections, Infant pneumonia L 1, L 2, L 3: Genital infection Giemsa stain showing cytoplasmic inclusions

Developmental Cycle of Chlamydia/Chlamydophila Found in two stages Elementary body (EB) – infectious, survives outside of host (extracellular) Reticulate bodies (RB) – noninfectious, intracytoplasmic, reproductive form Host cell ingests an elementary body (EB) by endocytosis No phagosome-lysosome fusion. EB differentiates to form a reticulate body (RB) RB replicates by binary fission to form a mature inclusion RB cells may adopt a non-replicating, non-infectious persistent form Otherwise the RBs re-differentiate into EBs Release of EBs by lysis of the host cell, after which other cell types can be infected 85

Reservoir = infected humans Most common in military bases and college campuses (crowding) Transmission = respiratory droplets Pathogenesis= Intracellular growth Atypical pneumonia (walking pneumonia) Causes bronchitis, sinusitis and pneumonia. Chlamydophila pneumoniae Replicates in endothelial cells, endothelial cells of coronary arteries, smooth muscle cells, and macrophages. Has been demonstrated in atherosclerotic plaques—possible role in atherosclerosis. Lab tests: 1. Inflammatory cells, no organisms seen on Gram’s stain 2. Serology: Microimmunofluorescence / ELISA Treatment: Macrolides and tetracycline

Manifestations of Chlamydia trachomatis D-K serotypes in children Mother infected with chlamydia: Cervicitis/ PID Infection transmitted to new born during birth Ophthalmia neonatorum/ Conjunctivitis Infantile pneumonia : fever, rhinitis, staccato cough, difficulty in breathing

Chlamydophila psittaci � Causes Psittacosis/ Ornithosis/Parrot Fever � Associated with parrots , parakeets, cockatoos, macaws, turkeys � Mode of Infection: Inhalation of dust contaminated with birds secretions/ feces. � Dissemination from primary respiratory site to blood and RE system with intense lymphocytic response. � C/F: fever, atypical pneumonia (bilateral interstitial pneumonia) and may be associated with hepatomegaly, endocarditis, myocarditis, encephalitis and even death � Diagnosis: Serological tests: Microimmunofluorescence/ ELISA � Treatment: Doxycycline � Prevention: avoid birds

Legionnaire’s Disease Legionella pneumophila Scientists named the bacterium after an outbreak in Philadelphia in 1976. During that outbreak, many people who went to an American Legion convention got sick with pneumonia (lung infection). 89

Epidemiology and Trends Outbreaks are commonly associated with buildings or structures that have complex water systems, like hotels and resorts, long-term care facilities, hospitals, and cruise ships. About one in 10 people who gets sick from Legionnaires’ disease will die Can be transmitted in the hospital set up Keeping Legionella out of water systems in buildings is key to preventing infection. 90

Case � A community hospital is experiencing an increased incidence of nosocomial pneumonias. Most cases occur in patients with long hospitalizations. � Symptoms include- shortness of breath, fatigue, nonproductive cough and fever. Signs- Rales bilaterally and dullness at base of right lung � Lab findings- Leukocytosis, Hyponatremia � Microbiology lab findings� Sputum microscopy-bacilli observed with silver stain, � Sputum culture- grow on a complex medium-BCYE agar Diagnosis: Legionnaires’ Disease � What is the possible diagnosis? Causative agent? 91

Epidemiology and Transmission No human transmission seen 92

Pontiac Fever �Mild form of Legionella infection �Flu-like symptoms Not this This one ↓ �Usually self-limiting 93


Legionella pneumophila �Weakly staining GNR, better stained with silver stain � Fastidious � Aerobic, motile � 12 serogroups, serogroup 1 most common �Fresh water-loving organism �Facultative intracellular pathogen � Multiples in macrophages Legionnaires’ Disease and Pontiac Fever �Low virulence �Risk groups: older smokers with high alcohol intake, immunocompromised 95

Legionnaires’ Disease Pathogenesis 1) Adheres to respiratory epithelium 2) Attaches to alveolar macrophages coiling phagocytosis 3) Prevents phagosomelysosome fusion 4) Replication inside the macrophage 5) Lysis of phagocytes q Hydrolytic enzymes Lung damage and inflammatory response Reproduced from: Swanson MS, Hammer BK, 2000. Legionella pneumophila pathogesesis: a fateful journey from amoebae to macrophages. Annu. Rev. Microbiol. 54: 567 -613. Legionella is a facultative intracellular pathogen Major role in immunity—cell mediated; Minor role: Humoral immunity 96

Legionnaires’ Disease – Diagnosis �Microscopy �Poorly staining GNR �Direct fluorescent antibody (DFA) �Silver stain �Culture �Fastidious Fluoresceinlabeled antibody attached to Legionella bacilli BCYE � Requires cysteine and iron � Buffered charcoal yeast extract (BCYE) (Legionella rides its Bi. CYcl. E) �Urinary antigen test �Serogroup 1 only Legionella urinary antigen card 97

Legionnaires’ Disease Treatment and Prevention • Treatment ▫ Azithromycin ▫ Levofloxacin • Prevention ▫ Disinfection of water systems 98

Coxiella burnetii POTENTIAL BIOTERRORISM AGENT �Obligate intracellular GNR �Stain poorly � Forms spore-like stage for environmental survival �Reservoirs �Mammals (especially farm animals) � High concentration in placenta �Can survive in soil and milk for years �Transmission �Inhalation of airborne particles containing spores �Zoonotic � Risk factor = occupational exposure to animals

Coxiella burnetii – Pathology, Diagnosis and Treatment �Q fever �Asymptomatic �Pathogenesis �Intracellular survival �Self-limiting flu-like syndrome �Atypical pneumonia � Non-productive cough �Hepatitis �Diagnosis �Serology �Treatment �Doxycyline

FYI: Obligate Intracellular Organisms �RACE inside when it’s cold: �Rickettsia �Anaplasma �Chlamydophila and Coxiella �Ehrlichia

What did Rickettsia say to Coxiella? Thankyou! 102

References � Murray’s Medical Microbiology 8 th edition: Ch. 19 - Streptococcus pneumoniae Ch. 21 - Bacillus anthracis Ch. 25 - Klebsiella pneumoniae Ch. 27 - Pseudomonas aeruginosa, Stenotrophomonas and Burkholderia Ch. 29 - Bordetella pertussis, Legionella pneumophila Ch. 33 - Mycoplasma pneumoniae Ch. 34 - Coxiella burnetii Ch. 35 - Chlamydophila pneumoniae and C. psittaci � Other references � Up. To. Date website: www. uptodate. com � CDC website: www. cdc. gov � Nature Reviews Microbiology � Kaplan’s Comlex Level 1 Immunology and Microbiology � Robbins Basic Pathology, 9 th Ed. , Chapter 12, pp. 486 -493 103

Extras Provided to assist your studies 104

Pseudomonas aeruginosa Pathogenesis Return 105

Altered Penicillin Binding Proteins Beta-lactam antibiotics bind to enzymes (PBPs) required for cell wall synthesis. Alteration of PBPs decreases binding of drug and increases bacterial resistance. Back to S. pneumoniae 106
Optochin Susceptibility Test for Streptococcus pneumoniae A positive presumptive identification of S. pneumoniae is made when a well defined zone of inhibition results around the impregnated disk. Other alpha-hemolytic streptococci do not display this clear zone of inhibition when in the presence of optochin. The chemical tests the fragility of the bacterial cell membrane and causes S. pneumoniae to lyse due to changes in surface tension. Back to S. pneumoniae 107

Complement Fixation Back to Chlamydia 108
- Slides: 108